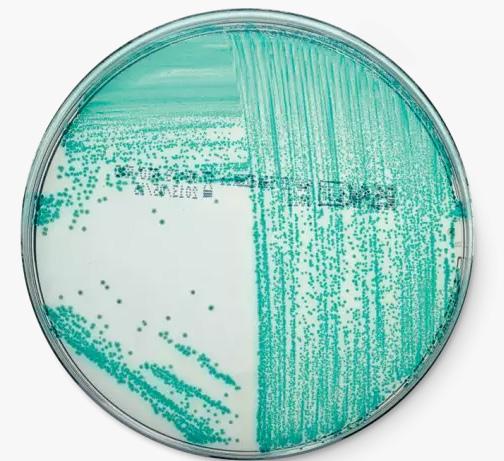

NR. 10, OKTOBER


CRONOBACTER
ER JERES OVERFLADER OVERHOVEDET RENE?
Side 2-3
Side 4-5
UNDGÅ SNYD MED ANIMALSKE FØDEVARER Side 6-7

![]()


CRONOBACTER
ER JERES OVERFLADER OVERHOVEDET RENE?
Side 2-3
Side 4-5
UNDGÅ SNYD MED ANIMALSKE FØDEVARER Side 6-7


• Cronobacter spp. (tidligere Enterobacter sakazakii) er patogene bakterier, der findes naturligt i miljøet, og som kan forårsage fødevarebårne sygdomme
• De kan leve på overflader (f.eks. køkkenborde, vaske, brystpumper, flasker og udstyr til fødevarefremstilling)
• De er særligt gode til at overleve i tørre produkter i pulverform, som f.eks. modermælkserstatning, mælkepulver, urtete og stivelse
• De er uskadelige for de fleste mennesker, men kan forårsage livstruende infektioner hos spædbørn.
PIF-supplementet anvendes sammen med Buffered Peptonvand (BPW) til opformering af Enterobacteriaceae, specielt Salmonella spp. og Cronobacter spp.
I Forordning 2073/2005 (med ændringer) om mikrobiologiske kriterier for fødevarer, er der derfor også defineret et fødevaresikkerhedskriterium for Cronobacter spp. I “Tørrede modermælkserstatninger eller tørrede fødevarer til særlige medicinske formål bestemt til spædbørn på under seks måneder”. Alle udtagne Cronobacter-prøver skal være negative/10g i holdbarhedsperioden.
Der foretages desuden paralleltest for Enterobakterier.
Cronobacter kan forårsage infektioner i blodbanen og centralnervesystemet, som henholdsvis sepsis og meningitis. Komplikationer af Cronobacter-infektion hos spædbørn kan omfatte hjerneabsces, udviklingsforsinkelser, motoriske svækkelser og død.
Symptomer relateret til Cronobacter-infektion hos spædbørn kan omfatte dårlig ernæring, irritabilitet, temperaturændringer, gulsot, gryntende vejrtrækninger eller unormale kropsbevægelser.
PIF-supplement kan anvendes til prøver med høj baggrundsflora, som eksempelvis mælkesyrebakterier, Bifidobakterier og andre gram-positive bakterier.
I lande udenfor EU findes der ofte også grænseværdier for Cronobacter. I nogle tilfælde skal prøverne være negative i en væsentligt større prøvemængde end i EU. Det er også ofte tilladt at “poole” (sammenlægge) prøver, så man ender op med en relativt stor prøvemængde - helt op til 375g. Til en prøve i den størrelse skal der bruges 3375ml opformeringsvæske, hvilket er krævende for både pengepung og rygmuskler. MEN – det er heldigvis muligt at anvende PIF-supplement.
Det er særligt velegnet til detektion af Salmonella spp. og Cronobacter spp. i modermælkserstatning og spædbørnsernæring med eller uden probiotika, ingredienser til disse produkter og til miljøprøver fra produktion.
Ved anvendelse af PIF-supplement er det muligt at opformere op til 375g og samtidig nøjes med en fortynding på 1:4.
Når der anvendes PIF-supplement, vil der derfor kun skulle anvendes 1125ml BPW og 150 µl rehydreret PIF-supplement. Altså en besparelse på 2250 ml BPW pr. prøve.
Vi anbefaler som udgangspunkt to forskellige måder at detektere Cronobacter på.
Kort fortalt:
• Samtidig påvisning af Cronobacter og Salmonella i en enkelt opformering
• Stor prøvestørrelse (op til 375 g)
• Fortyndingsforhold 1:4 i stedet for 1:10
• Afnor-validerede applikationer til både iQ-Check Real-Time PCR-løsninger og RAPID chromogene medier


•Chromogent medie: RAPID’Sakazakii indeholder 5-bromo4-chloro-3-indolyl α-D-glucopyranosid, som hydrolyseres ved Cronobacters enzymaktivitet. Dette resulterer i blå/blågrønne kolonier.
Natriumdeoxylat, krystalviolet, samt den høje inkubationstemperatur (44°C), er med til at inhibere følgefloraen.
• Real time PCR: iQ-Check Cronobacter spp. med 96 brønde. Kittet indeholder lysis reagens, fluorescerende prober, amplifikations mix, samt positiv og negativ kontrol.
Begge analysemetoder kan anvendes til både rå- og færdigvarer (typisk mælkepulver eller modermælkserstatning), samt miljøprøver.

Kontakt vores produktspecialist for mere information

Ehsan Mirsharghi
Ehsan@fooddiagnostics.dk Tlf: 22 22 75 92

Test for proteinrester efter rengøring
Selv små spor af allergifremkaldende stoffer i mad kan fremkalde allergiske reaktioner. Derfor er overvågning af jeres rengøring og effektiviteten heraf på produktionslinjer en vigtig del af kvalitetskontrollen i fødevareindustrien.
En hurtig og nem metode til at afgøre renheden af en overflade. Testen er en svabertest, som detekterer proteinrester. Overfladen svabres, og testen aktiveres ved at “knække” halsen og frigive reagens. Ved tilstedeværelse af proteiner skifter reagenset farve fra grøn til lilla. Jo mere protein på overfladen, jo hurtigere indtræder farveskiftet til lilla, og farven bliver dybere.
AllerSnap™ anvendes som generel kontrol for, om proteinbaserede allergener er fjernet fra produk- tionsoverflader efter rengøring.
Detektionsgrænsen er 3 ug protein (kræver inkubation i 30 min. ved 37°C).
Hvordan håndteres overflade- og rengøringskontrollen bedst?
Der findes forskellige måder, hvorpå man kan gå til kontrollen af sin overfladerengøring på, alt efter om man ønsker at teste for et specifikt allergen, eller hvor hurtigt man ønsker at have et svar på sin analyse.
Få her et overblik over 3 forskellige tilgange til kontrol af jeres overfladerengøring:
1. AllerSnap™
AllerSnap™ giver mulighed for hurtigt at kunne tage aktion på en ikke tilstrækkeligt rengjort overflade, vha. et farvekodesystem.
•Grøn betyder ren.
•Farveskift til lilla angiver, at overfladen bør rengøres igen.

Rene og kontrollerede produktionsbetingelser er en forudsætning for allergenfrie fødevareprodukter.
Derfor bør der, specielt på produktbærende overflader i en fødevareproduktion, hvor der anvendes flere forskellige allergener i forskellige produkter, anvendes svabere eller lateral flow tests. Når disse produkter anvendes, påkræves der intet laboratorieudstyr, og resultaterne fra disse tests er samtidig tilgængelige indenfor 30 min.
Man kan vælge at teste for proteinrester (stort set alle allergener i Mærkningsbekendtgørelsen er proteiner) eller efter specifikke allergener.
Fordele ved svaber- og lateral flow test:
• On-site testing (test direkte i produktionen)
• Nemt at gå til – kræver ikke noget laboratorie
•Simpel og hurtig prøveforberedelse


Pro-Clean™ fungerer præcis som AllerSnap™, dog med en højere detektionsgrænse.
• Detektionsgrænsen er 80 µg protein efter 1 min. ved stuetemperatur.
• Detektionsgrænsen er 50 µg protein efter 5 min. ved stuetemperatur.
• Detektionsgrænsen er 20 µg protein efter 10 min. ved stuetemperatur.
Fordelen ved at gøre brug af denne test er, at den er en smule hurtigere (få resultatet efter 1-10 min.), og at den kan inkuberes ved stuetemperatur.
Se video om, hvordan proteintests virker og hvordan man udtager prøven på den rigtige måde:


Hvis det er vigtigt at kontrollere for specifikke allergener, er lateral flow tests det rigtige valg.
De kan fås til mange af de allergener, som er nævnt i Mærkningslovgivningen, f.eks. gluten, mælk og æg. Spørg os gerne for information om den komplette liste.
For at kunne anvende Lateral Flow er det ikke påkrævet at have noget laboratorieudstyr, og resultaterne fra disse immunokromatografiske tests er tilgængelige inden for 5 – 10 min.


Kontakt vores produktspecialist for mere information
Kontakt vores produktspecialister for mere information
Thomas Bundgaard
Thomas Bundgaard
thomasb@fooddiagnostics.dk
Thomasb@fooddiagnostics.dk

Tlf: 4268 7218
Tlf: 42 68 72 18





Vores mad er ikke altid det, vi tror det er. Tilfælde af fødevaresvindel dukker op med jævne mellemrum.
Normalt henviser udtrykket fødevaresvindel til en bevidst forfalskning af mad med økonomisk gevinst. Dette inkluderer substitution, tilsætning, manipulation eller forkert gengivelse af mad eller fødevareingredienser - for eksempel fortynding af mælk med vand, blanding af oksekød med hestekød eller ulovlig mærkning.
Fødevarestyrelsen angiver følgende kriterier for fødevaresvindel:
1.Overtrædelse af fødevarelovgivningen
2.Begået forsætligt
3.For at opnå økonomisk gevinst
4.Ved at snyde kunderne
Selvom der ikke findes nogen nøjagtige data, anslås det, at ca. 10% af alle kommercielt solgte fødevarer kan være udsat for svindel. De hyppigste forfalskede fødevarer inkluderer fisk, honning, olivenolie, mælk, krydderier, frugtsaft, kaffe, te og kød.
Normalt udgør fødevaresvindel ingen risiko for menneskers sundhed - i de fleste tilfælde er den eneste konsekvens, at forbrugeren betaler prisen for et produkt af høj kvalitet, men kun modtager et produkt af lav kvalitet. Madsvindel kan imidlertid være livstruende for allergiske personer, hvis umærkede allergener kommer ind i produktet - for eksempel når en pose med hakkede mandler blandes med jordnødder.
Tredjepartscertificeringer beskriver typisk at man skal sikre sig mod "Food fraud". En anden mulighed er garantien for religiøse diætregler (halal & kosher m.v.).
Der findes en række forskellige metoder til afsløring af fødevaresvindel, de fleste af disse metoder kan detektere ned til 1% af den uønskede fødevare – PCR-løsninger helt ned til 0,1%.
Vigtigste fordele ved at overvåge fødevaresvindel
•Forbrugerbeskyttelse: Sikrer, at forbrugerne ikke bliver vildledt af falsk mærkning, og at de modtager de produkter, de forventer.
•Overholdelse af lovgivning: Hjælper producenter med at overholde fødevaresikkerhedsbestemmelserne og undgå juridiske konsekvenser.
•Kvalitetssikring: Bevarer fødevaremærkernes integritet og omdømme ved at sikre produktets ægthed og kvalitet.
•Økonomiske besparelser: Reducerer risikoen for dyre tilbagekaldelser og potentielle økonomiske tab på grund af forfalskning.
•Avancerede detektionsmetoder: Anvender teknologier såsom real-time PCR til nøjagtigt at identificere og kvantificere forfalskningsstoffer i fødevarer.
Overvågning af fødevareforfalskning er afgørende for at bevare forbrugernes tillid og sikkerhed samt fødevareproducenternes omdømme. Ved at implementere avancerede detektionsmetoder, kan virksomheder sikre ægtheden og kvaliteten af deres produkter, overholde regulatoriske standarder og beskytte sig selv mod økonomiske tab. Effektiv testning af food fraud er en hjørnesten i moderne fødevaresikkerhedsstyring, der hjælper med at opretholde de højeste standarder for kvalitet og forbrugerbeskyttelse.
Simple og let anvendelige kits, som kan bruges uden at have et laboratorie.
Fås til kontrol for okse, gris, hest, får og fjerkræ.
Til Pangasius - en fisk som blandes med andre fisk, da den er meget billig - findes et nemt lateral flow kit.


PCR
ELISA giver mulighed for at analysere for indhold af en lang række dyrearter, både enkeltvis og flere på samme tid.
Desuden findes der også mulighed for at analysere varmebehandlet kød, samt benmel.
SureFood® Animal ID produktlinjen giver mulighed for sensitiv testning af svinekød, oksekød, hest, æsel, kylling, kalkun og andre arter.
Mange af kittene er multiplex, dvs. at de kan detektere 2 eller 3 forskellige arter i samme PCR-kørsel.
For liste over de tilgængelige kits, scan QR-koden



Kontakt vores produktspecialist for mere information


Kontakt vores Tech Support for mere information
Katarina Petrucic
Michelle Frandsen
Katarina@fooddiagnostics.dk
michelle@fooddiagnostics.dk
Tlf: 25 94 80 86
+45 2040 7099
Et mikrobiologisk kriterium består af syv betingelser eller elementer:
• Fødevare
• Mikroorganisme
• Led i produktionen, hvor kriteriet gælder

Biokemi
• Prøveudtagningsplan
Færøerne
Danmark
• Analysemetode
• Grænseværdi
skrides, skal produkterne som udgangspunkt enten trækkes tilbage fra markedet og eventuelt også tilbagekaldes fra den endelige forbruger. Fødevare- sikkerhedskriterier gælder også for fødevarer fra et andet EU-land eller fra et tredjeland.
Danmark
Runi Nielsen Tonny NielEhsan Mirsharghi Mikrobiologi

Thomas Bundgaard Hygiejne
Cristiana@foodiagnostics.dk Telefon: 2594 8086
• Opfølgning, hvis grænseværdien er overskredet
Runi@foodiagnostics.dk Telefon: (298) 591667
KOMMISSIONENS FORORDNING (EF) Nr. 2073/2005 af 15. november 2005 om mikrobiologiske kriterier for fødevarer beskriver 2 forskellige kriterier:
Fødevaresikkerhedskriterium: angiver en grænse for, hvornår et produkt eller et parti fødevarer vurderes acceptabelt ud fra en fødevaresikkerhedsmæssig vurdering. Fødevaresikkerhedskriterier gælder for fødevarer, når de er markedsført, og indtil holdbarhedstiden udløber. Hvis kriteriet over-
Danmark
Ehsan@foodiagnostics.dk Telefon: 2222 7592 Hygiejne & ECA
Tonny@foodiagnostics.dk Telefon: 4056 5659
Proceshygiejnekriterium: angiver et acceptabelt mål for virksomhedens produktionshygiejne. Hvis grænseværdien overskrides, skal der iværksættes korrigerende handlinger således, at proceshygiejnen fortsat kan være i overensstemmelse med fødevarelovgivningen. Et proceshygiejnekriterium gælder på specifikke produktionstrin eller ved afslutning af produktionen. Et proceshygiejnekriterium gælder ikke for markedsførte produkter og derfor heller ikke for produkter indført fra EU-lande og tredjelande.
Se, hvad vores tilfredse kunder siger om os!
Vi har lagt fire kundevideoer op på vores hjemmeside. Se dem her




Danmark
thomasb@fooddiagnostics.dk
Tlf: 42 68 72 18

Ehsan Mirshargi
Mikrobiologi
Danmark
ehsan@fooddiagnostics.dk
Tlf: 22 22 75 92

Katarina Petrucic
BioKemi
Danmark
katarina@fooddiagnostics.dk
Tlf: 25 94 80 86

Sofie Jeppesen
Techsupport
Danmark
sofie@fooddiagnostics.dk
Tlf: 87 59 16 66
Food Diagnostics A/S
Søndre Kajgade 7-9
8500 Grenaa
Danmark
Tlf: 8759 1666
Mail: info@fooddiagnostics.dk
På www.fooddiagnostics.dk og tilmeld dig vores digitale nyhedsbrev eller ’’følg’’ os på Facebook, Linkedln eller YouTube



